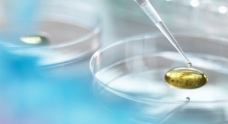
株式会社Japan Medical Hempのプレスリリース

【レアカンナビノイド】最高品質カンナビノイドのプレミアム原料 卸販売を開始 Dr.GREEN LABS_株式会社 Japan Medical Hemp
品質を追求することにより生まれる圧倒的な「体感」 最高レベルにまで品質を高めることにより、弊社の製品は他社製品との圧倒的な差・体感を得ることができます。 世界最先端の科学技術を用いて抽出された、大麻に含有される合法成分"CBD"を中心にCBN,CBG,CBCなど人気のレアカンナビノイドまで取り揃えています。 https://japanmedicalhemp.com/ https://drgreen-labs.com/
Japan Medical Hempが総代理店契約を結んでいる世界最先端のカンナビノイド企業と研究・開発した、レアカンナビノイドのプレミアム原料を販売開始いたします。
弊社で取り扱う原料は、オーガニックなヘンプより抽出されます。
原料の生産は米国国務省により認定された生産者により栽培されており、すべてのバッチは生産元の農場まで追跡可能です。
少量のサンプル購入から受け付けていますので、この機会に本物の圧倒的な品質をお試しください。
■取り扱い原料
・CBG Distillate
・CBN Distillate
・THCV
・CBC
・CBDA
・Premium Full Spectrum Distillate
・Nano CBD
・CBD
・テルペン
etc...
【CBG DISTILLATE】
CBG 87.7% / THC 0% / Total Cannabinoids 90.20%
・麻由来の天然テルペン含有
・made in USA
・COA(第三者機関によるフルパネル成分分析表取得済み)
・SDS
・成熟証明書
【CBN DISTILLATE】
CBN 99.9% / THC 0% / Total Cannabinoids 99%
・麻由来の天然テルペン含有
・made in USA
・COA(第三者機関によるフルパネル成分分析表取得済み)
・SDS
・成熟証明書
【THCV ISOLATE】
THCV 96% / THC 0% / Total Cannabinoids 96%
・made in USA
・COA(第三者機関によるフルパネル成分分析表取得済み)
・SDS
・成熟証明書
■使用例
・電子タバコ(ベイプ)、水タバコ(シーシャ)
・食品(飲料、グミ、キャンディー、クッキー、コーヒーなど)
・化粧品、雑貨など
■品質基準
・100%天然成分 (オーガニック)
・食品等級 (最高品質・安心安全)
・COA 取得
・SDS 取得
・ISO9001
※厚生省の許可検査を得て輸入しています。
※違法成分なども非検出、安心安全にご使用できます。
■お問い合わせ
株式会社Japan Medical Hemp
担当:佐々木
TEL:090-2473-7755
E-Mail:info@japanmedicalhemp.jp
ログインするとメディアの方限定で公開されている
お問い合わせ先や情報がご覧いただけます
添付画像・資料
添付画像をまとめてダウンロード
企業情報
| 企業名 | 株式会社Japan Medical Hemp |
|---|---|
| 代表者名 | 佐々木謙一 |
| 業種 | その他サービス |